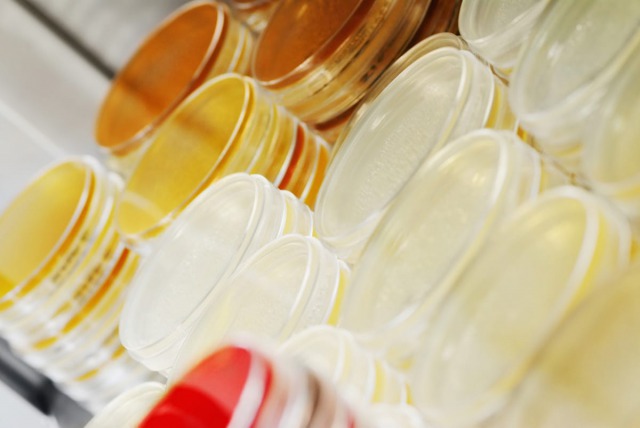

Wie zijn wij?
Het ministerie van Volksgezondheid Welzijn en Sport (VWS) is in 2016 de regionale aanpak antibioticaresistentie (ABR) gestart. Een belangrijk onderdeel van deze aanpak is de oprichting van tien Regionale Zorgnetwerken ABR met als doel antibioticaresistentie te voorkomen en verspreiding te bestrijden op regionaal niveau.
ABR Zorgnetwerk Holland West is één van deze zorgnetwerken.
Wanneer verzamelen wij uw persoonsgegevens?
Wij verzamelen uw gegevens vanaf het moment dat u zich inschrijft voor onze nieuwsbrief of voor één van onze bijeenkomsten.
Waarom verzamelen wij uw persoonsgegevens?
Wij verzamelen en verwerken uw gegevens voor het versturen van onze nieuwsbrieven en/of het organiseren van bijeenkomsten waar u zich voor aangemeld heeft of heeft aangegeven hierin geïnteresseerd te zijn.
Welke persoonsgegevens verzamelen wij van u?
De persoonsgegevens die wij verwerken voor bijeenkomsten zijn hieronder vermeld. U bent zelf verantwoordelijk voor juistheid en relevantie van de gegevens die u verstrekt.
- NAW gegevens, bedrijfsgegevens, functie, (e-mail)adres en andere contactgegevens;
- BIG registratie voor het toekennen van accreditatiepunten.
- voor bijeenkomsten waarbij een maaltijd wordt verzorgd kan eveneens informatie over uw allergie of maaltijdvoorkeuren worden verwerkt.
De persoonsgegevens worden uitsluitend gedeeld met de personen belast met het organiseren van de bijeenkomsten. Voor het organiseren van deze congressen kan gebruik gemaakt worden van een extern bureau. Als er gebruik wordt gemaakt van een extern bureau dan heeft het ABR-zorgnetwerk hiermee afspraken gemaakt zodat uw persoonsgegevens overeenkomstig de AVG worden verwerkt.
Bewaartermijn persoonsgegevens
Wij zullen uw gegevens vier weken na de eventuele evaluatie van de bijeenkomst verwijderen, tenzij er een nieuwe vervolgbijeenkomst wordt gepland. In dat geval worden uw gegevens vier weken na de evaluatie van de laatste bijeenkomst vernietigd. Bij het aanmelden voor een bijeenkomst kan een andere bewaartermijn vermeld worden.
Rechten
U heeft recht op inzage in uw persoonsgegevens en het recht om correctie, verwijdering of overdracht van uw persoonsgegevens te vragen. Daarnaast heeft u het recht om bezwaar te maken tegen het verwerken van uw gegevens.
Als u wilt weten welke persoonsgegevens het ABR-zorgnetwerk van u verwerkt, dan kunt u een schriftelijk inzageverzoek doen. Het ABR-zorgnetwerk behandelt uw verzoek binnen 4 weken. Blijkt dat uw gegevens onjuist, onvolledig of niet relevant zijn? Dan kunt u een aanvullend verzoek doen om uw gegevens te laten wijzigen of aan te vullen.
U kunt uw schriftelijke verzoek sturen aan:
RDOG Hollands Midden / t.a.v. ABR Zorgnetwerk Holland West
Postbus 121, 2300 AC Leiden
Mocht u het niet eens zijn met de wijze waarop het ABR-zorgnetwerk omgaat met uw persoonsgegevens dan kunt u een klacht indienen bij de Autoriteit Persoonsgegevens.
Vragen
Heeft u na het lezen van dit privacy statement nog vragen, geeft u dit dan aan via contact@amrhollandwest.nl waarna wij u in contact brengen met onze Privacy Officer.
Wijzigingen
Het ABR-zorgnetwerk behoudt zich het recht voor om dit privacy statement aan te passen. U kunt het meest actuele privacy statement opvragen via contact@amrhollandwest.nl. Indien het ABR-zorgnetwerk een belangrijke wijziging doorvoert, die gevolgen heeft voor de wijze waarop zij persoonsgegevens verwerkt, dan zullen wij dit kenbaar maken via onze nieuwsbrief.
Site
Op deze site is, met uw toestemming, Google Analytics actief om geannonimiseerde browsegegevens bij te houden. Met deze informatie kunnen we onze dienstverlening verbeteren. Meer informatie vindt u bij Google.